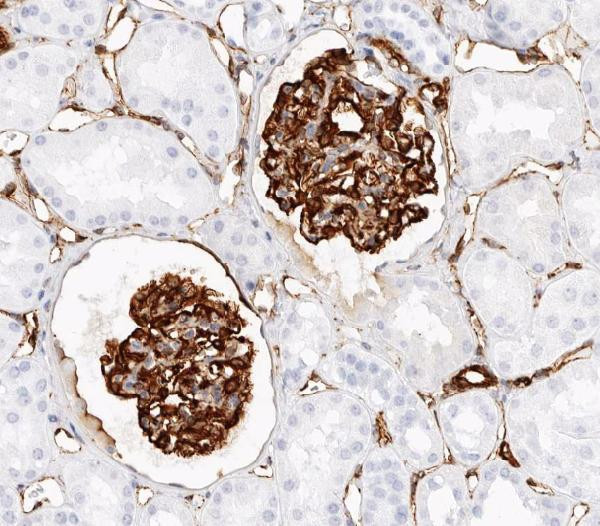
Nestin Antibody in Immunohistochemistry (Paraffin) (IHC (P))

Search
Invitrogen
Nestin Polyclonal Antibody
{{$productOrderCtrl.translations['antibody.pdp.commerceCard.promotion.promotions']}}
{{$productOrderCtrl.translations['antibody.pdp.commerceCard.promotion.viewpromo']}}
{{$productOrderCtrl.translations['antibody.pdp.commerceCard.promotion.promocode']}}: {{promo.promoCode}} {{promo.promoTitle}} {{promo.promoDescription}}. {{$productOrderCtrl.translations['antibody.pdp.commerceCard.promotion.learnmore']}}
图: 1 / 7
Nestin Antibody (PA5-79729) in IHC (P)







Please note: We are reviewing Western blot images included in the antibody testing data in our catalog, including those provided by third parties. Unless expressly labeled or annotated as “raw-unedited”, Western blot images included in the antibody testing data in our catalog may have been edited, optimized or otherwise adjusted for presentation.
产品信息
PA5-79729
种属反应
宿主/亚型
分类
类型
抗原
偶联物
形式
浓度
规格
纯化类型
保存液
内含物
保存条件
运输条件
RRID
产品详细信息
Reconstitute with 0.2 mL of distilled water to yield a concentration of 500 µg/mL.
Positive Control - WB: HELA whole cell, HEPG2 whole cell. IHC: rat kidney tissue, human melanoma tissue, rat kidney tissue IHC-F: mouse kidney tissue, rat kidney tissue.
靶标信息
Nestin is a Class VI intermediate filament abundantly produced in the developing central nervous system (CNS) and in early embryonic neuroepithelial stem cells. Nestin has been widely used as a predominant marker for stem/progenitor cells, glioma cells, and tumor endothelial cells. Also, Nestin is a superior angiogenic marker to evaluate neovascularity of endothelial cells in tumors. Highly specific antibodies to human Nestin can aid in characterizing progenitor cells differentiating into distinct lineages, in enhancing the therapeutic potential of human neural stem/progenitor cells in the treatment of CNS diseases or injury, and in identifying neuroepithelial tumor cells. Nestin expression has been observed in pancreatic hematopoietic stem cell populations, and is considered a novel angiogenesis marker of proliferating endothelial cells in colorectal cancer tissue.
仅用于科研。不用于诊断过程。未经明确授权不得转售。
篇参考文献 (0)
生物信息学
蛋白别名: FLJ21841; intermediate filament protein; Nestin
基因别名: AA166324; C78523; ESTM46; Nbla00170; NES
UniProt ID: (Mouse) Q6P5H2
Entrez Gene ID: (Rat) 25491, (Mouse) 18008